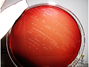

Créé en janvier 2001, Wikipédia est rapidement devenue la plus célèbre encyclopédie universelle.
Basée sur le volontariat et la collaboration, elle recense aujourd’hui plus de 187 millions d’articles édités dans plus de 280 langues. La version française compte 2.3 millions d’articles, plus de 15 millions d’utilisateurs uniques/mois et 800 000 pages vues/heure (chiffres 2016).
Wikipédia est désormais le cinquième site le plus fréquenté au monde, y compris par la communauté scientifique. La fiche de Wikipédia est souvent la première réponse donnée par Google à une requête quelconque. Faites le test avec n’importe quel sujet… mais aussi avec Agriculture, Élevage, Épuration des eaux, Génie écologique, et autres thèmes portés par INRAE.
C’est un moyen rapide et performant pour toucher tous les acteurs de la société intéressés sur les sujets en lien avec vos travaux. Tout contenu écrit qui enrichit un article dans la base Wikipédia doit être sourcé en se référant à différents supports : site web, ouvrage, publication scientifique ou technique, article de presse, vidéo etc. Il s’agit donc d’une belle opportunité pour mettre en avant vos travaux, notamment vis-à-vis de vos partenaires, voire de vos financeurs.
Histoire vraie : une équipe scientifique travaillant sur les poissons migrateurs a publié de nombreux documents sur la réhabilitation d’une espèce emblématique des cours d’eau. Au cours d’une réunion avec l’un de leurs principaux financeurs institutionnels, un des représentants de cette institution a indiqué s’être informé en amont de la rencontre sur le sujet en consultant la page Wikipédia de l’espèce en question, et non pas les nombreux articles produits par les scientifiques ! Autant dire que ladite page a été ensuite très vite actualisée avec des données récentes issues des laboratoires.
Une autre façon de contribuer à Wikipédia est de diffuser des photos ou autres illustrations de science (graphique, infographie, tableau par exemple) avec une légende bien décrite et sourcée. La plateforme permettant de déposer ce type de production visuelle se dénomme Wikimedia commons.
Voici à titre d’exemples deux photos de l’INSERM disponibles sous licence CC-BY-SA :
Souches de Roseburia intestinalis cultivées in vitro
Souches de Roseburia intestinalis cultivées in vitro
 Nouvelles techniques d’imagerie optique de la cornée
Nouvelles techniques d’imagerie optique de la cornée
Dans la fiche Focus OSCAR, découvrez comment créer un compte et contribuer à Wikipédia.
